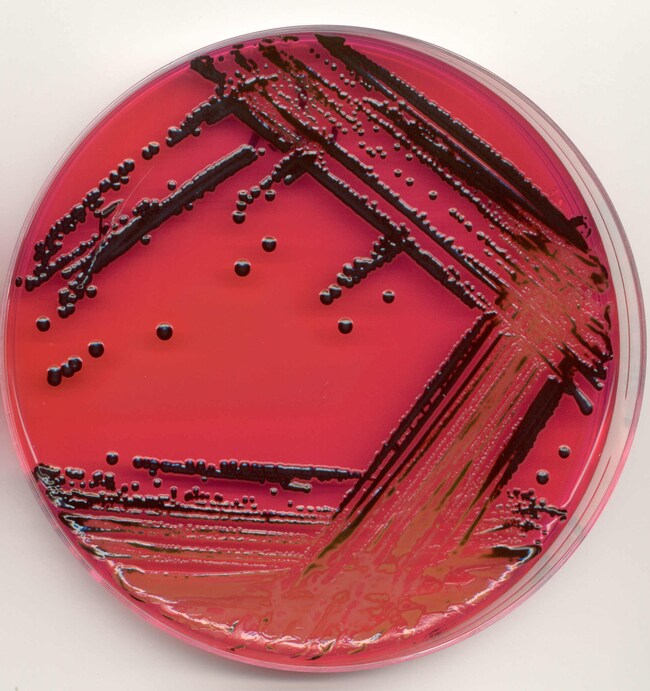
XLT-4 琼脂

Search
Thermo Scientific™
XLT-4 琼脂
使用可减少假阳性情况的具有高度选择性的 Thermo Scientific™ XLT-4 琼脂从临床、环境和食品样品中高效分离沙门氏菌并进行鉴定。
| 货号 | 数量 | 描述 |
|---|---|---|
| CM1061T | 5 kg | XLT-4 琼脂 |
| CM1061B | 500 g | XLT-4 琼脂 |
货号 CM1061T
价格(CNY)申请报价
-
数量:
5 kg
描述:
XLT-4 琼脂
使用高度选择性的 Thermo Scientific™ XLT-4 琼脂,可从临床、环境和食品样品中高效分离并鉴别沙门氏菌。 XLT-4 琼脂含有 Tergitol™ 4,其作用是抑制背景菌群微生物的生长,因为背景菌群微生物的生长可能导致在其它沙门氏菌平板培养基上进行区分时会出现问题。增强选择性,能够显著提高沙门氏菌的回收率,同时减少假阳性疑似菌落,节约时间,并降低进一步鉴别假阳性菌落的成本1。
XLT-4 琼脂是具有高度选择性的平板培养基,用于根据 Miller 和 Tate1 的方法从临床、环境和食品样品中分离和鉴定沙门氏菌。与其它沙门氏菌平板培养基相比,XLT-4 琼脂已显示出能够节约时间,并降低进一步鉴定假定假阳性菌落的成本1。
该配方中的蛋白胨和酵母菌提取物是氨基氮以及必需营养成分和维生素的来源;确保最适合沙门氏菌生长。
该选择剂是十四烷基硫酸钠,是一种阴离子型表面活性剂。它可以很大程度上抑制或减少不需要的本底菌群的生长。由于含有酚红,平板的本底色为红色,由于发酵和脱羟反应造成 pH 值发生变化,颜色也将随之变化。
木糖、乳糖和蔗糖的发酵作用以及赖氨酸的脱羟作用有助于在该培养基上进行区分。沙门氏菌显示为黑色或红色菌落,中心为黑色,它能够减少硫化氢的硫代硫酸盐,所以会引起菌落变黑(因为存在铁离子)。大肠杆菌能够发酵配方中的乳糖,所以成长为黄色菌落,引起 pH 值下降,使苯酚指示剂的颜色从红色变为黄色。其它微生物,比如志贺菌,不会发酵乳糖,或者减少硫代硫酸盐,所以显示为红色菌落,未变黑。
部分国家或地区尚未销售赛默飞世尔科技的全部产品。详情请具体咨询。
Remel™ 和 Oxoid™ 产品现已归属 Thermo Scientific 品牌旗下,将强大的手动、半自动化以及全自动化检测产品与全面的培养基和诊断产品系列相结合,带来完整的端到端解决方案,能够快速交付您所需的产品以及您的实验室所倚重的高质量结果。
- 确保最适合沙门氏菌生长,同时减少假阳性疑似菌落
- 使用十四烷基硫酸钠抑制不需要的本底菌落
- 可以轻松区别沙门氏菌:显示为黑色或红色菌落,中心为黑色
该配方中的蛋白胨和酵母菌提取物是氨基氮以及必需营养成分和维生素的来源;确保最适合沙门氏菌生长。
该选择剂是十四烷基硫酸钠,是一种阴离子型表面活性剂。它可以很大程度上抑制或减少不需要的本底菌群的生长。由于含有酚红,平板的本底色为红色,由于发酵和脱羟反应造成 pH 值发生变化,颜色也将随之变化。
木糖、乳糖和蔗糖的发酵作用以及赖氨酸的脱羟作用有助于在该培养基上进行区分。沙门氏菌显示为黑色或红色菌落,中心为黑色,它能够减少硫化氢的硫代硫酸盐,所以会引起菌落变黑(因为存在铁离子)。大肠杆菌能够发酵配方中的乳糖,所以成长为黄色菌落,引起 pH 值下降,使苯酚指示剂的颜色从红色变为黄色。其它微生物,比如志贺菌,不会发酵乳糖,或者减少硫代硫酸盐,所以显示为红色菌落,未变黑。
部分国家或地区尚未销售赛默飞世尔科技的全部产品。详情请具体咨询。
Remel™ 和 Oxoid™ 产品现已归属 Thermo Scientific 品牌旗下,将强大的手动、半自动化以及全自动化检测产品与全面的培养基和诊断产品系列相结合,带来完整的端到端解决方案,能够快速交付您所需的产品以及您的实验室所倚重的高质量结果。
仅限实验室使用
一般参考文献:
- Dusch, H. and Altwegg, C. J. of Clin. Micro. Apr. 1995, p.802-804. Vol 33, No. 4
- Miller, R.G., Tate, C.R. (1990) The Maryland Poultryman, April: 2-7
规格
颜色草黄色
描述XLT-4 琼脂
数量5 kg
形式粉末
原料来源英国
产品类型Media Broth
Unit SizeEach
内容与储存
10°C 至 30°C